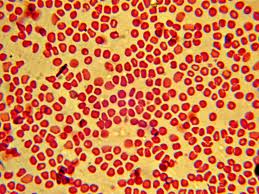

La Sangre Es Homogénea O Heterogénea

El rendimiento de la reacción si se producen 14 70 g de nitrógeno c.
La sangre es homogénea o heterogénea. La sangre es una mezcla homogénea. La masa de nitrógeno obtenida b. Porfavor especifiquen porque gracias. Homogénea hace referencia a la solución que resulta de una mezcla completamente uniforme de dos o más elementos.
La sangre es una mezcla heterogénea pero sus componentes no se pueden distinguir a simple vista la única forma de distinguirlos es mediante un análisis de sangre y empleando un microscopio ya que no es perceptible para el ojo humano. La sangre es una mezcla heterogénea daniela8267 daniela8267 homogéneahdhshwvhshedh. La sangre es una mezcla homogénea o heterogénea. En una mezcla homogénea todos los elementos se unen hasta el punto en que se hace difícil distinguir uno del otro.
Un sistema puede ser homogéneo o heterogéneo según el tamaño de la muestra que se analice o según el sistema de observación utilizado para determinar sus propiedades. La sangre es una mezcla heterogénea pero sus componentes no se pueden distinguir a simple vista. La razón por la que es una mezcla homogénea es debido a que no podemos distinguir a simple vista todos los componentes que se encuentran disueltos en ella. En la sangre se observan.
Un ejemplo de soluto es el café molido que se mezcla con agua caliente para preparar una taza de café. Para el ojo humano se considera como una mezcla homogénea. La masa que no reaccionó del reactante la reacción. La principal característica de una mezcla homogénea es que si se divide entonces quedan cantidades iguales de.
Respuesta la sangre es una mezcla explicación la sangre es una mezcla debido a que es la unión entre plasma glóbulos y células eso quiere decir que no están combinados químicamente por lo que no es posible considerarla como un compuesto químico además de no tener una formula química. La sangre es un elemento compuesto mezcla homogenea o mezcla heterogénea 2. La única forma de distinguirlos es mediante un análisis de sangre y empleando un microscopio ya que no es perceptible para el ojo humano. Homogenea ya que nosotros no podemos ver lo que la contiene a simple vista encambio si fuese heterogenea pudiesenos ver lo que la contiene por separado y a simple vista.
La sangre es una mezcla homogenea o heterogenea. Doy 5 estrellas y coronaayudaa por favoor se hacen reaccionar 40 g de hidracina n2 h4 con 42 g de agua oxigenada h2o2 según la ecuación n2h4 h 2o2 n2 h2ocalcula a. Encuentra respuesta a tu tarea ahora en tareas gratis. Para el ojo humano se considera como una mezcla homogénea.
La sangre es un compuesto. Añade tu respuesta y gana puntos.